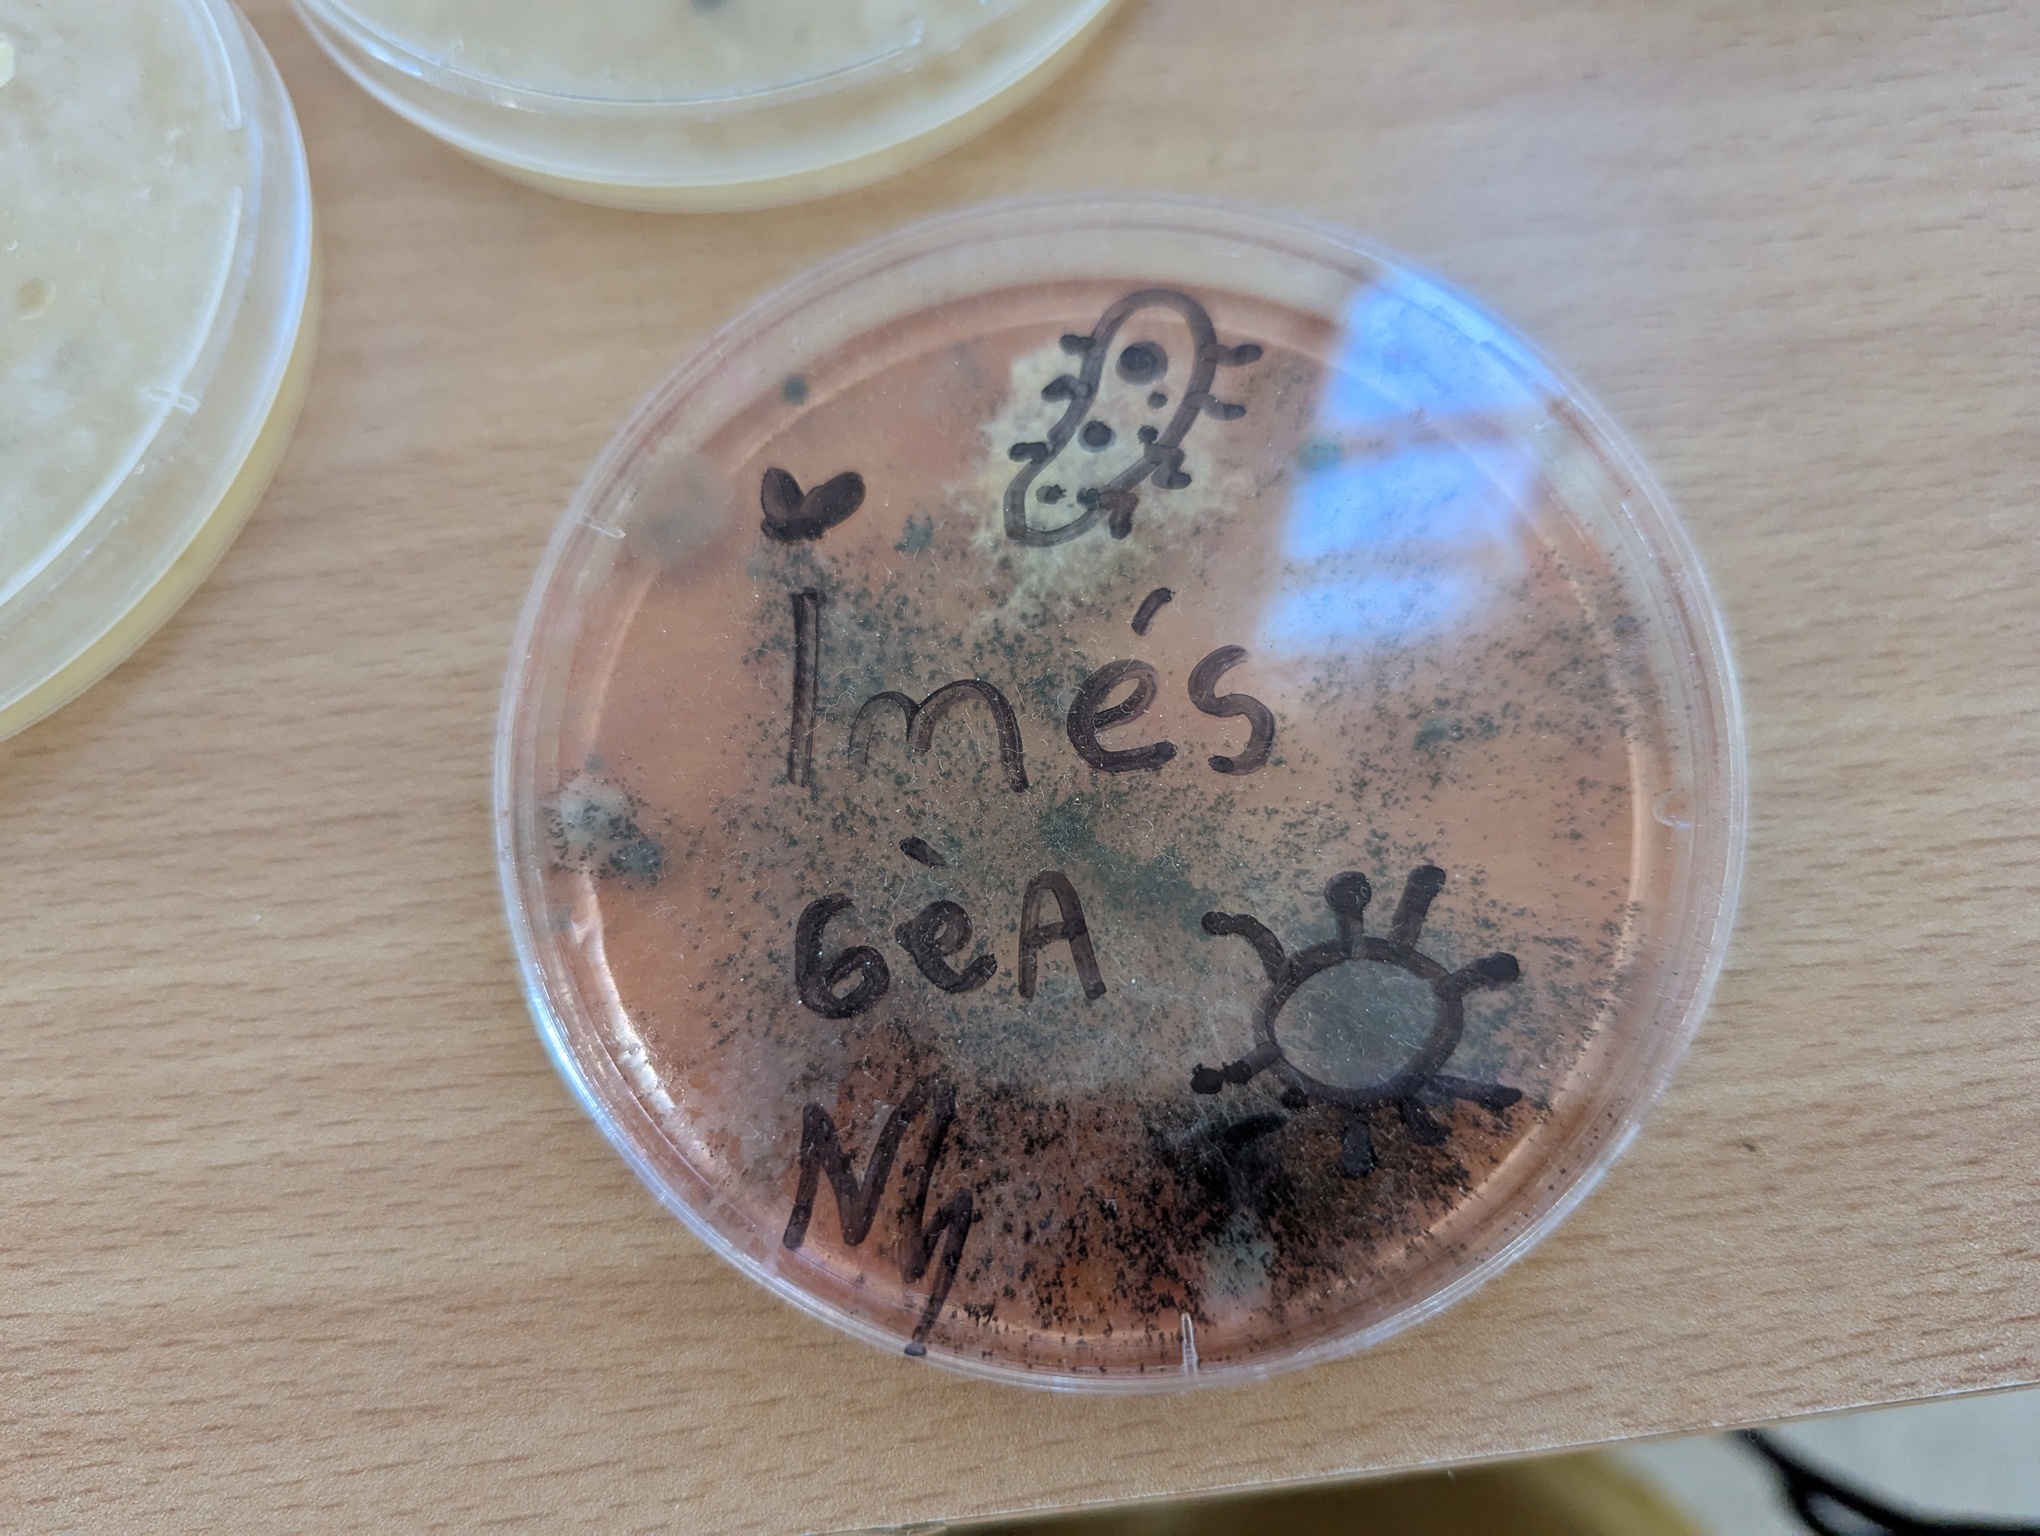
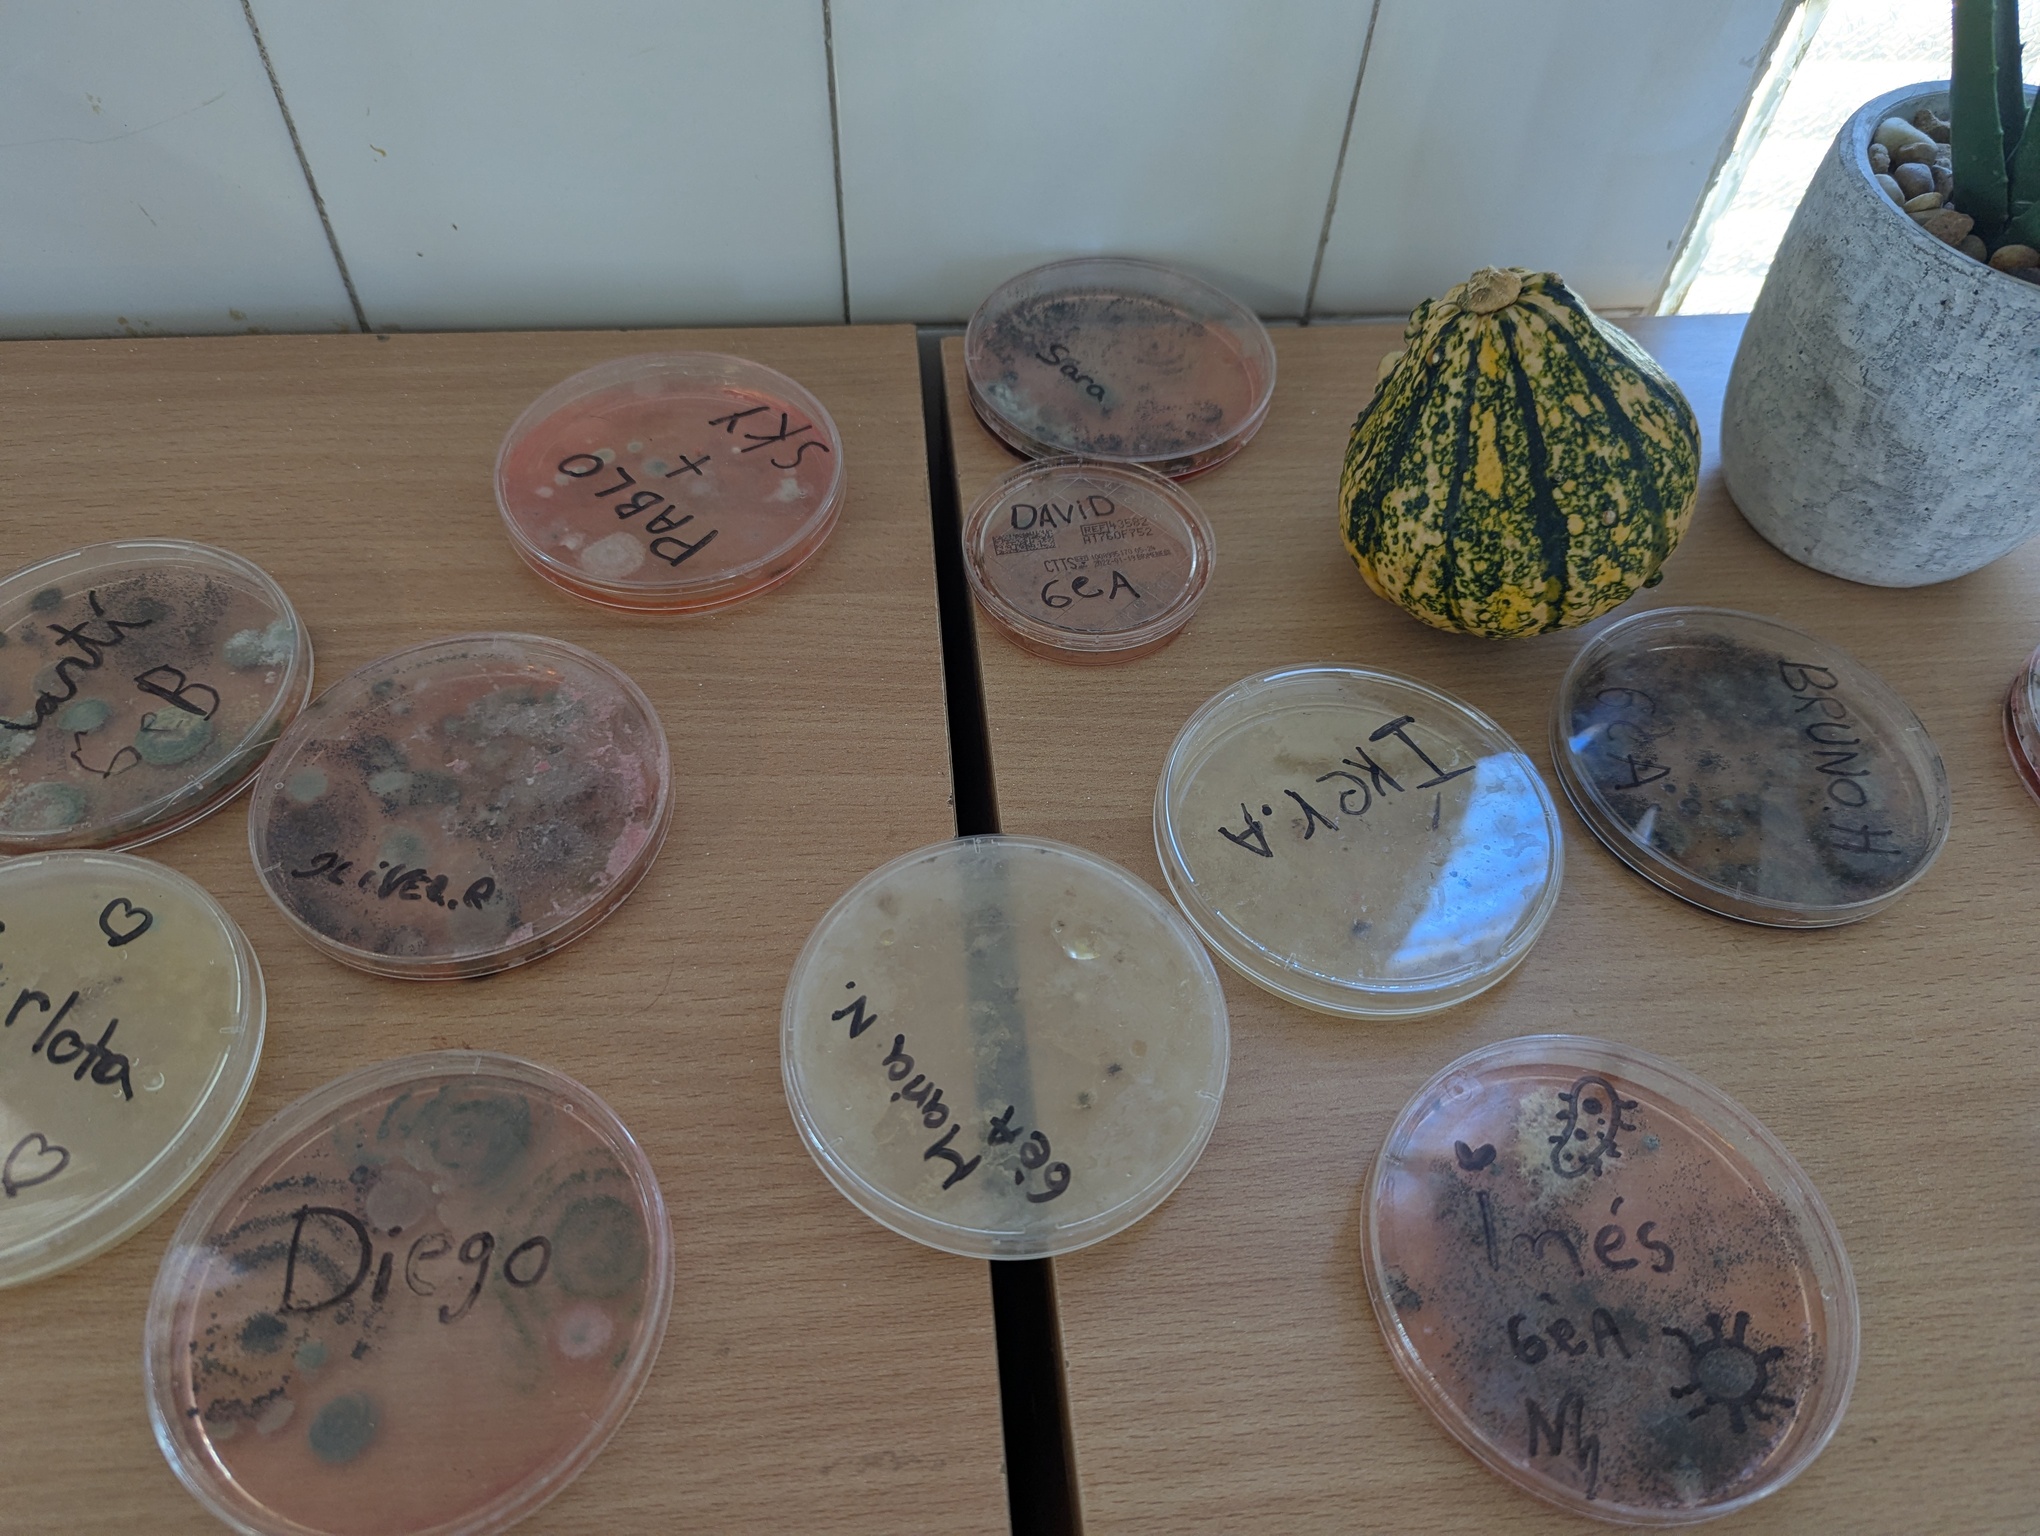

L’alumnat de sisè de primària ha estat immers en un apassionant projecte sobre la cèl·lula, el microscopi i els òrgans del cos humà. A través d’una mirada STEAM, els nois i noies han combinat ciència i creativitat per entendre millor com funcionem per dins.
Després d’observar mostres amb el microscopi i estudiar les diferents parts de la cèl·lula, han dut a terme una activitat artística sorprenent: la recreació d’òrgans humans amb plastilina i altres materials. L’estómac, el cervell, l’epidermis, els intestins… tots ells han pres forma a les seves mans, amb un realisme que gairebé semblava de veritat!
Aquesta experiència ha permès treballar de manera interdisciplinària, connectant la ciència amb l’art, la tecnologia i la curiositat científica. Els infants han après experimentant, observant i creant, tot desenvolupant el pensament crític i la capacitat d’expressar el coneixement de forma creativa.
Una mostra més que aprendre pot ser fascinant quan es fa amb entusiasme, experimentació i una mirada oberta al món que ens envolta.

Comentaris recents